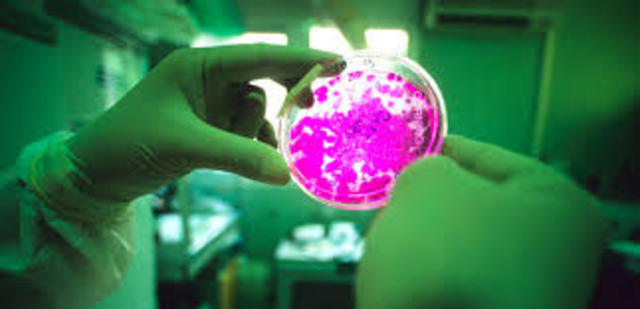
first human liver grown from stem cells in Japan

-
-
One of the most important contributions to medicine from medieval China was to creation of amalgams for dental procedures. A text from the year 659 details the first use of a substance for tooth fillings, which was made up of silver and tin.
http://www.medievalists.net/2015/11/top-10-medical-advances-from-the-middle-ages/ -
The first pharmacy was established in Baghdad in the year 754. The pharmacist prepares compounded medications as prescribed and ordered by the prescribing physician.
-
He composed the Kitāb al-shifāʾ (Book of the Cure), a vast philosophical and scientific encyclopaedia, and Al-Qānūn fī al-ṭibb (The Canon of Medicine), which is among the most famous books in the history of medicine. (980 AD - 1037)
https://www.britannica.com/biography/Avicenna -
Not sure who invented eyeglasses, but they were made in 1305 to correct vision.. The first pair were not seen worn until 1352
-
While cesarean sections were practiced throughout the Middle Ages, this was done because the mother had died or had no chance of survival – and in some cases where the child was also already dead. But around the year 1500 we have the first written record of having both a mother and baby surviving a cesarean section.
http://www.medievalists.net/2015/11/top-10-medical-advances-from-the-middle-ages/ -
-
the study of the structure of an object, in this case the human body. Human anatomy deals with the way the parts of humans, from molecules to bones, interact to form a functional unit. The study of anatomy is distinct from the study of physiology, although the two are often paired.
-
Andreas Vesalius (31 December 1514 – 15 October 1564) was a 16th-century Flemish/Netherlandish anatomist, physician, and author of one of the most influential books on human anatomy, De humani corporis fabrica (On the Fabric of the Human Body). Vesalius is often referred to as the founder of modern human anatomy.
-
an Italian Renaissance polymath whose areas of interest included invention, painting, sculpting, architecture, science, music, mathematics, engineering, literature, anatomy, geology, astronomy, botany, writing, history, and cartography
-
Zacharius Jannssen invents the microscope
-
Antoni van Leeuwenhoek is widely credited as the discoverer of red blood cells. In truth, he was not the first person to observe "red particles" in blood but his observations were more detailed and numerous than those (by Malpighi and Swammerdam) that preceded him
-
the period of progress in European medical knowlage
-
gave the first smallpox inoculations
-
performed the first successful appendectomy
-
Developed a smallpox vaccination method
-
-
Edward Jenner develops the process of vaccination for smallpox, the first vaccine for any disease
-
Discovered the anestethic properties of nitrous oxide
-
It consisted of a wooden tube and was monaural. Laennec invented the stethoscope because he was uncomfortable placing his ear on women's chests to hear heart sounds.
-
A dentist named William T. G. Morton was the first in the world to publicly demonstrate the use of ether anesthesia for surgery. Morton performed a painless surgery removing a tumor from a man's neck.
-
Medical Imaging began with radiography after the discovery of x-rays by Wilhelm Röntgen, a German professor of physics. X-rays were put to diagnostic use very early, before the dangers of ionizing radiation were discovered.
-
Alzheimer's disease is named after Dr. Alois Alzheimer. In 1906, Dr. Alzheimer noticed changes in the brain tissue of a woman who had died of an unusual mental illness. Her symptoms included memory loss, language problems, and unpredictable behavior.
-
-
the sleeping sickness is a tropical disease caused by a parasitic protozoan (trypanosome) that is transmitted by the bite of the tsetse fly. It causes fever, chills, pain in the limbs, and anemia, and eventually affects the nervous system causing extreme lethargy and death.
-
Edward Mellanby discovered vitamin D and shows that its absence causes rickets
-
insulin was first used in the treatment of diabetes. Insulin was discovered by Sir Frederick G Banting, Charles H Best and JJR Macleod at the University of Toronto in 1921 and it was subsequently purified by James B Collip.
-
He was an American physician, surgeon, and medical researcher. He researched in the field of blood transfusions, developing improved techniques for blood storage, and applied his expert knowledge to developing large-scale blood banks early in World War II.
-
an antiretroviral medication used to prevent and treat HIV/AIDS. It is generally recommended for use with other antiretrovirals. It may be used to prevent mother-to-child spread during birth or after a needlestick injury or other potential exposure.
-
-
used sterile maggots for infectios wound treatment
-
The first HPV vaccine was approved in 2006. HPV is the abbreviation for Human Papilloma Virus. HPV vaccines may prevent infection by certain types of humans papillomavirus which are associated with the development of cervical cancer, genital warts, and other cancers.
-
AbioCor was a total artificial heart (TAH) developed by the Massachusetts-based company AbioMed. It was fully implantable within a patient, due to a combination of advances in miniaturization, biosensors, plastics and energy transfer.
-
Scientists in Japan said they had grown human liver tissue from stem cells in a first that holds promise for alleviating the critical shortage of donor organs.
Creating lab-grown tissue to replenish organs damaged by accident or disease is a Holy Grail for the pioneering field of research into the premature cells known as stem cells. -
First cases and deaths in Europe and America
Looking for a timeline maker?
Create timelines for projects, roadmaps, history, lessons, legal cases, and stories with Timetoast. Timetoast is a timeline maker for work, school, research, and stories.